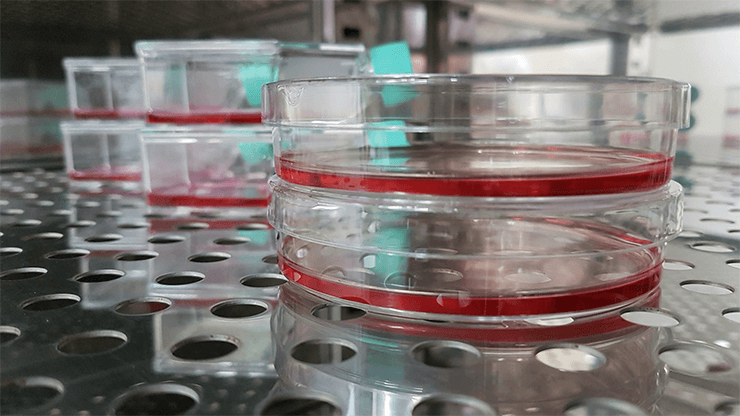
Стерилизация посуды, сред и окружения для культивирования

Мы приняли вашу заявку, свяжемся с вами в ближайшее время.

История
Часть товаров из корзины будет перемещена в статус отложенных и не сможет быть оформлена для заказа, если вы продолжите работу в данном регионе
История

История
История

Содержание статьи:
Большинство научных исследований в области биологии и медицины проводятся не на живых организмах, а "в пробирке". Клеточные культуры и культуры микроорганизмов являются наиболее простым и удобным модельным объектом, позволяющим как тестировать на них воздействие извне, так и исправлять ошибки внутри клетки. Благодаря исследованиям в области клеточного редактирования постепенно становится возможным лечение многих генетических заболеваний. Но каким образом мы можем добиться культуры, максимально соответствующей требованиям к модели для сложных экспериментов? Рассмотрим наиболее популярные современные способы выращивания микроорганизмов и культур клеток.
Культивирование как микроорганизмов, так и отдельных клеток – это выращивание изъятого из определенной среды материала в лабораторных условиях. Выращенная таким образом подборка единообразных микробов или клеток уже может называться культурой.
Для того, чтобы выращивание прошло успешно, требуется наличие определенного оборудования, а также соблюдение условий, необходимых для роста и созревания культуры. Стандартно для культивирования используются:
Также в процессе культивирования от лаборатории требуется соблюдение условий роста для каждой конкретной культуры. Ввиду того, что как клетки, так и микробы, требуют для себя условий, приближенных к естественным, в лаборатории должны поддерживаться различные условия роста при наличии разных культур. Основные условия: приемлемая для культур температура, влажность, давление, постоянная подача кислорода (для аэробных бактерий) или исключение доступа к кислороду (для анаэробных). (Рекомендуем статью: "Флуоресцентная микроскопия")

Факторами роста называют все питательные вещества, которые требуются бактериям и клеткам для оптимального роста и развития. В случае если сама среда не обладает достаточным количеством нужных элементов, их добавляют извне. При этом количество строго регулируется в зависимости от требований к конечной культуре.
К наиболее часто использующимся в современном лабораторном культивировании факторам роста относятся:
В зависимости от типа культивируемых клеток или бактерий, фактор роста может как входить в состав питательной среды, так и вноситься извне.
Питательная среда – это пространство, в котором находится необходимая группа клеток или бактерий. Среды бывают очень разными, в том числе и узкоспециализированными, для роста наиболее привередливых микроорганизмов. Однако существуют и общие требования, предъявляемые ко всем средам без исключения:
При этом питательные среды могут значительно различаться по всем остальным характеристикам. Они могут быть как натуральными, так и синтезированными искусственно, а также жидкими, полужидкими или плотными.
Рост микроорганизмов и клеток невозможен без соблюдения определенных условий, таких как температура, влажность, давление, свет и аэрация (насыщение кислородом). Существуют микроорганизмы, которые имеют диаметрально противоположные требования по условиям роста. Для решения проблемы условий при культивировании различных клеток или микроорганизмов используется специальная аппаратура с камерами, внутри которых поддерживается нужный уровень температуры, света или давления. В одном таком устройстве, но в разных камерах, может быть одновременно несколько чашек Петри с материалом, имеющим различные требования по условиям роста. (Рекомендуем статью: "Инновационные технологии для поиска и разработки новых лекарств")
Одним из наиболее важных требований к процессу культивирования, является отсутствие загрязнений на оборудовании, при помощи которого происходит выращивание. Этого добиваются, проводя мероприятия по стерилизации. Стерилизация может проводиться несколькими способами, наиболее известные и используемые в современных лабораториях:
Основным моментом в современном культивировании клеток и микроорганизмов, всегда будет являться неуниверсальность методик. Из-за большого разнообразия объектов культивирования, всегда будет необходимость подбирать наилучшие условия для конкретного объекта.
С помощью личного кабинета Вы сможете:
Сравнение